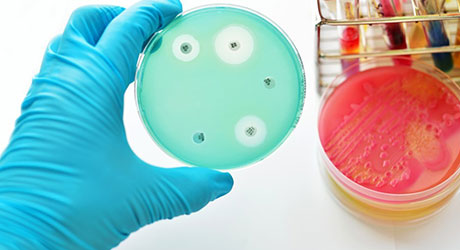
Shinogi Global Web 460

Fighting antibiotic resistance globally
The issue
Antibiotic resistance doesn’t respect borders. When used properly, antibiotics can change lives. Yet up to two billion people around the world still lack access to them. It’s important that people, wherever they live, have access to what the World Health Organisation deem the ‘essential’ antibiotics. It is also important to address hygiene and sanitary conditions in poorer countries, and to ensure that they have the right antibiotics they need to treat common infections.
The UK already funds projects overseas to help people with get antibiotics. Pharmaceutical companies work closely with governments around the world to strengthen their health systems and improve access to antibiotics. Companies are also work on surveillance programmes to collect data on how antibiotics are being used. They work with NGOs such as WHO and GAVI to support effective prevention strategies and make sure antibiotics and vaccines are available where and when they’re most needed.
The solution
Throughout the world, we must support access to essential medicines and vaccines, as well as education about routine infection prevention and control measures. It is also important that there are education programmes about the appropriate use of antibiotics and surveillance programmes to monitor local susceptibility of pathogens so we can monitor the emergence and spread of resistance.

MSD
Since 2008 MSD has worked with 1,100 hospitals in 28 countries, enabling around 10,000 healthcare providers to be trained and over 500 clinical treatment pathways to be implemented based on local hospital microbiological data.
MSD also operates one of the world’s largest and longest running surveillance studies, the Study for Monitoring Antimicrobial Resistance Trends (SMART), which since its inception in 2002, has collected over 200,000 isolates from 217 sites in 63 countries.
The data is made publicly available to the scientific research community as well as to innovators such as OpGen who are working to develop rapid diagnostics and information technology products.
Shionogi
Shionogi recognises the very real and growing threat of AMR globally, which is set to exceed the biggest current causes of death by 2050 unless action is taken. We have a long heritage in AMR with several molecules in the pipeline and are committed to working with stakeholders to address this growing issue.
Shionogi’s position paper outlines key calls to action to fight AMR in areas including global access to medicines, appropriate use of antibiotics, harmonisation of regulations for development, reduction of environmental impact, establishment of clinical trial networks and creation of a predictable market to stimulate R&D.

Pfizer
Pfizer supports antibiotic susceptibility testing and educational initiatives for healthcare professionals. In 2017, Pfizer launched the Antimicrobial Testing Leadership and Surveillance (ATLAS) website.
It’s one of the largest AMR surveillance programs in the world and has open access to healthcare workers, researchers and the global health community with easy access to critical resistance information informing them about resistance trends across more than 70 countries. The system spans 14 years of bacterial resistance monitoring involving over 240 active hospital sites across around 60 countries.
Pfizer
Pfizer are the main consortium sponsor for the British Society for Antimicrobial Chemotherapy (BSAC) Antimicrobial Stewardship open online courses, with seen 54,000 enrolled for courses across 200 countries.
Examples include BSAC stewardship courses and an educational app for healthcare professionals like Bye Bye Bugs, an educational game for junior doctors and pharmacists to help to increase their understanding of appropriate antimicrobial prescribing in an interactive and educational way.

If antibiotics no longer work, it would signal the end of modern medicine. It is now not enough to simply cut antibiotic use – we urgently need to find new ones to win the war against the superbugs that are resistant to multiple drugs. Professor Dame Sally Davies, UK Special Envoy on Antimicrobial Resistance
Last modified: 20 September 2023
Last reviewed: 20 September 2023
